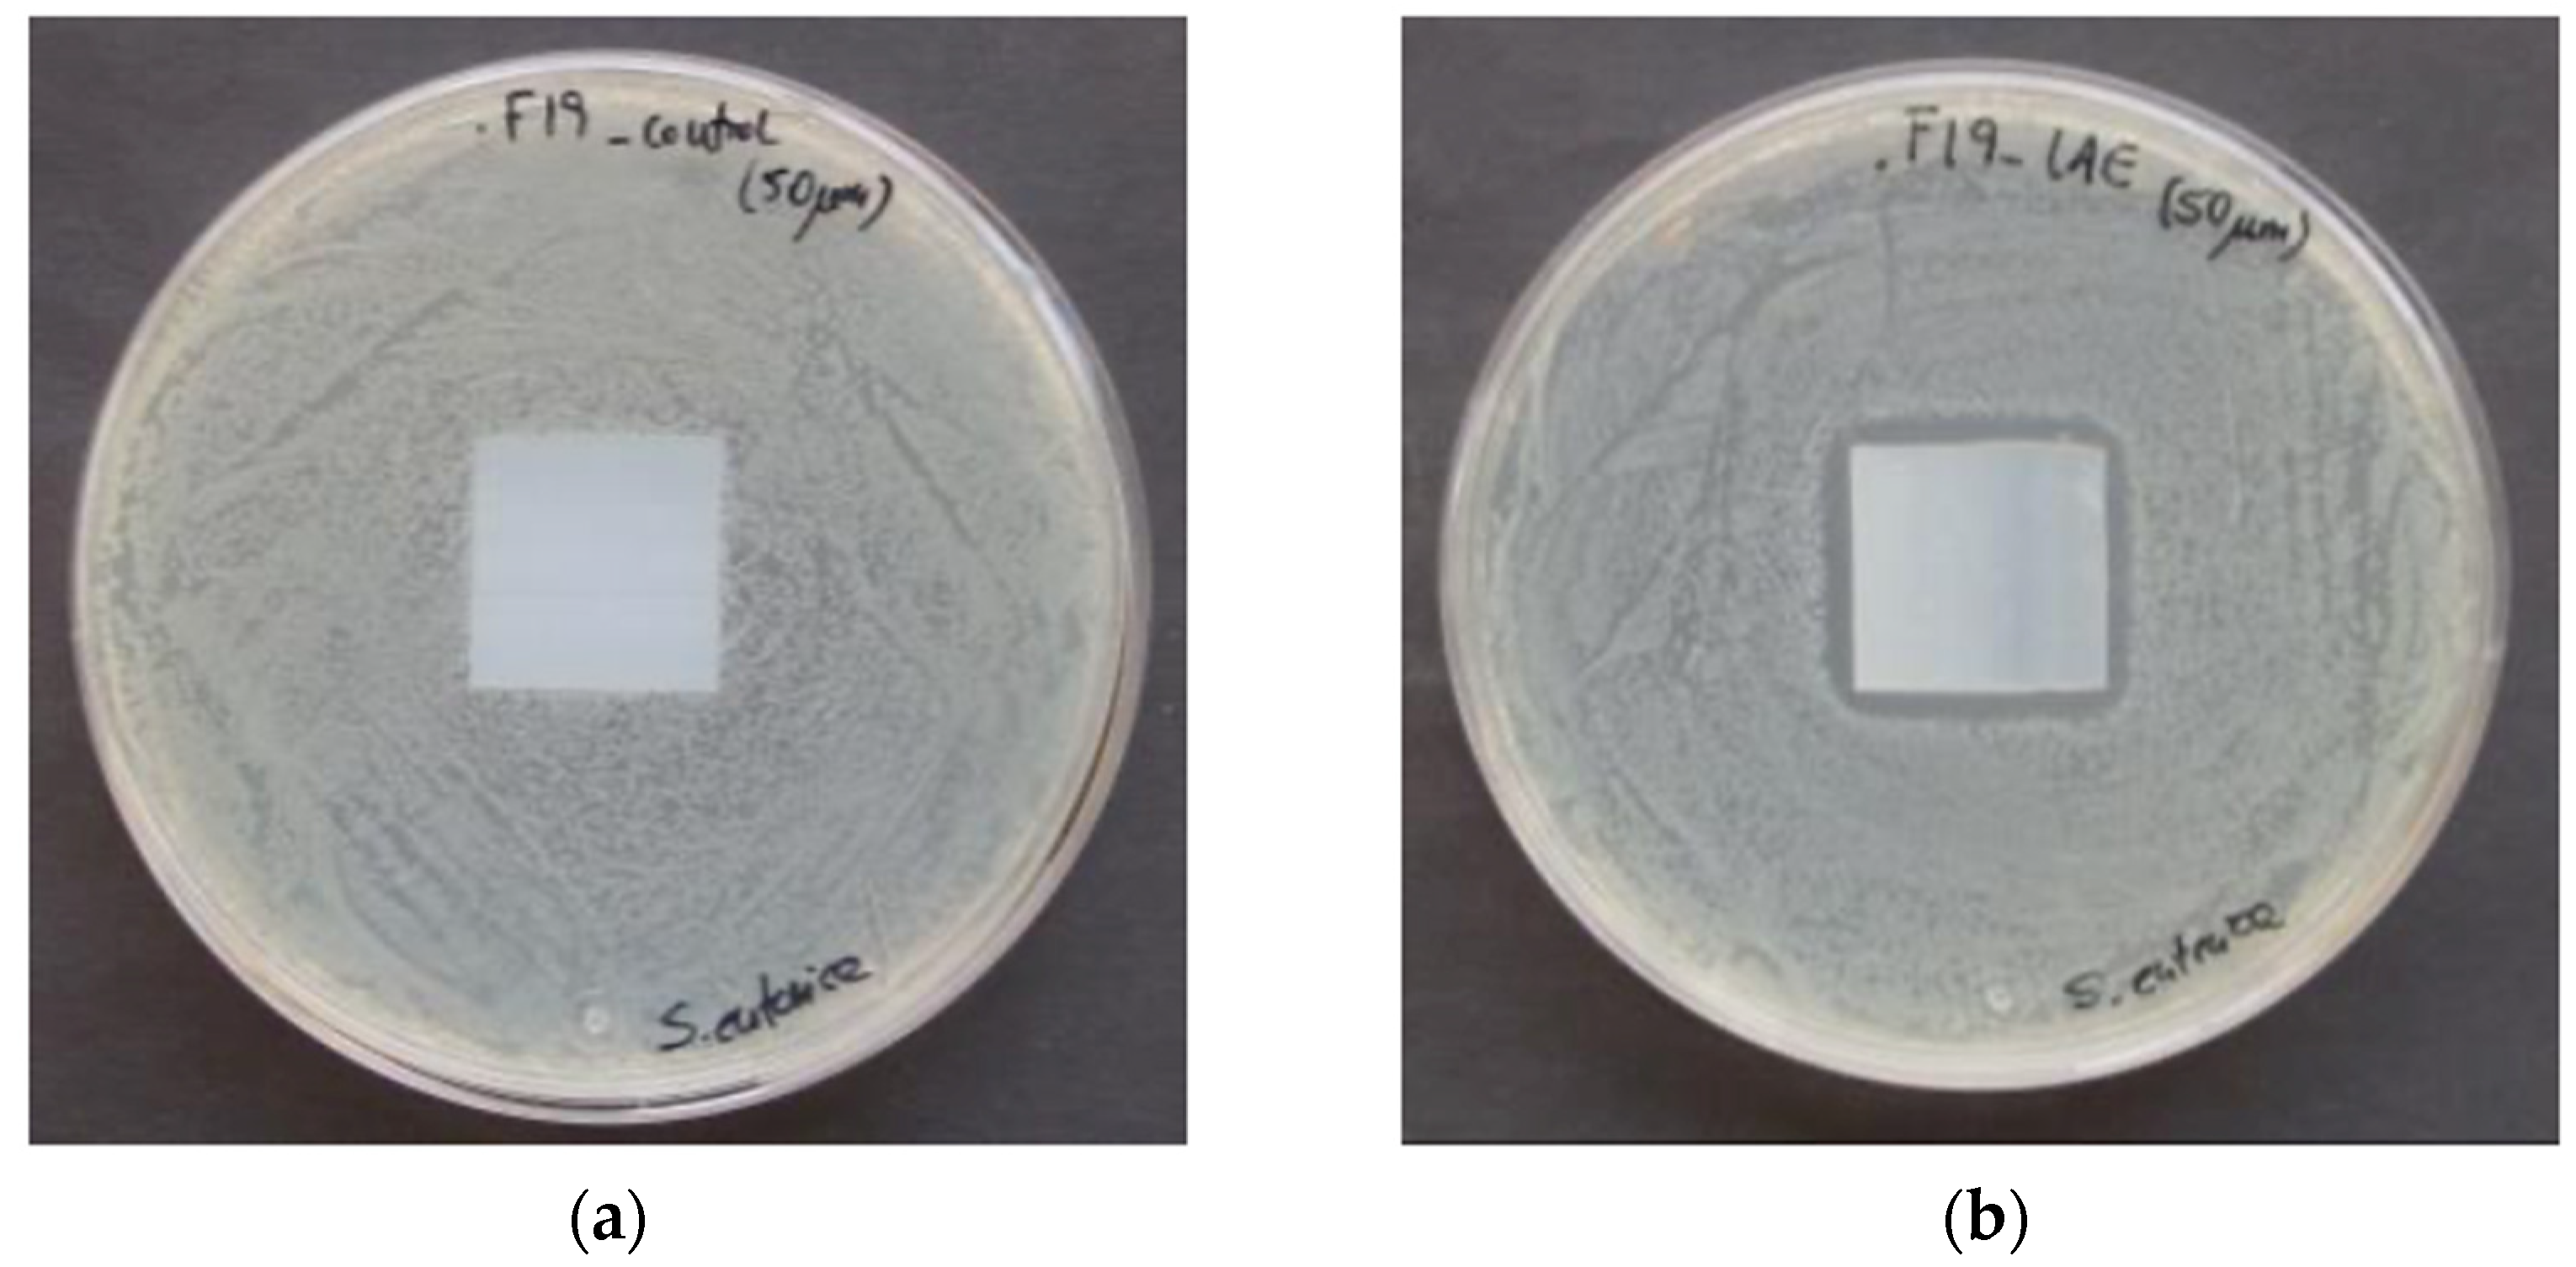
Polymers 13 00355 g004

Evaluation of New Antimicrobial Materials Incorporating Ethyl Lauroyl Arginate or Silver into Different Matrices, and Their Safety in Use as Potential Packaging
Abstract
:1. Introduction
2. Materials and Methods
2.1. Chemicals
2.2. Bacterial and Mold Strains
2.3. Antimicrobial Films Containing Ag and LAE
- BK—Blank LDPE
- Ag_20—LDPE film with incorporated 2% of IONPURE IPL (0.036% silver), 20 µm thickness
- Ag_50—LDPE film with incorporated 2% of IONPURE IPL (0.036% silver), 50 µm thickness
- BK—Blank INZEA F19 biofilm
- LAE_20—INZEA F19 biofilm with incorporated 6% of LAE, 20 µm thickness
- LAE_50—INZEA F19 biofilm with incorporated 6% of LAE, 50 µm thickness
2.4. LAE Polystyrene (PS) Foam Pads Preparation
2.5. Antimicrobial Activity of Silver-Containing Powder
2.6. Antimicrobial and Antifungal Activity of Silver Films
2.7. Assessment of Silver Release from the Active Films by ICP-MS
2.8. Antimicrobial Activity and Thermal Stability of LAE
2.9. Antimicrobial and Antifungal Activity of LAE Films
2.10. Antimicrobial Activity of LAE PS Pads
2.11. Statistics
3. Results and Discussion
3.1. Antimicrobial Activity of Silver Powder
3.2. Antimicrobial and Antifungal Activity of Silver Films
3.3. Release of Silver from Active Films by ICP-MS
3.4. Thermal Stability and Antimicrobial Activity of LAE
3.5. Antimicrobial and Antifungal Activity of LAE Films
3.6. Amount of LAE Present in PS Pads
3.7. Antimicrobial Activity of LAE PS Pads
4. Conclusions
Author Contributions
Funding
Institutional Review Board Statement
Informed Consent Statement
Data Availability Statement
Conflicts of Interest
References
- Zhong, Y.; Godwin, P.; Jin, Y.; Xiao, H. Biodegradable polymers and green-based antimicrobial packaging materials: A mini-review. Adv. Ind. Eng. Polym. Res. 2020, 3, 27–35. [Google Scholar] [CrossRef]
- Khaneghah, A.M.; Hashemi, S.M.B.; Limbo, S. Antimicrobial agents and packaging systems in antimicrobial active food packaging: An overview of approaches and interactions. Food Bioprod. Process. 2018, 111, 1–19. [Google Scholar] [CrossRef]
- Kerry, J.P. New Packaging Technologies, Materials and Formats for Fast-Moving Consumer Products. In Innovations in Food Packaging, 2nd ed.; Elsevier: Amsterdam, The Netherlands, 2013; ISBN 9780123946010. [Google Scholar]
- Kerry, J.P.; O’Grady, M.N.; Hogan, S.A. Past, current and potential utilisation of active and intelligent packaging systems for meat and muscle-based products: A review. Meat. Sci. 2006, 74, 113–130. [Google Scholar] [CrossRef] [PubMed]
- Nguyen Van Long, N.; Joly, C.; Dantigny, P. Active packaging with antifungal activities. Int. J. Food Microbiol. 2016, 220, 73–90. [Google Scholar] [CrossRef] [PubMed]
- Akrami, F.; Rodríguez-Lafuente, A.; Bentayeb, K.; Pezo, D.; Ghalebi, S.R.; Nerín, C. Antioxidant and antimicrobial active paper based on Zataria (Zataria multiflora) and two cumin cultivars (Cuminum cyminum). LWT Food Sci. Technol. 2015, 60, 929–933. [Google Scholar] [CrossRef]
- Gutiérrez, L.; Sánchez, C.; Batlle, R.; Nerín, C. New antimicrobial active package for bakery products. Trends Food Sci. Technol. 2009, 20, 92–99. [Google Scholar] [CrossRef]
- Lago, M.A.; Sendón, R.; de Quirós, A.R.B.; Sanches-Silva, A.; Costa, H.S.; Sánchez-Machado, D.I.; Valdez, H.S.; Angulo, I.; Aurrekoetxea, G.P.; Torrieri, E.; et al. Preparation and Characterization of Antimicrobial Films Based on Chitosan for Active Food Packaging Applications. Food Bioprocess Technol. 2014, 7, 2932–2941. [Google Scholar] [CrossRef]
- Manso, S.; Becerril, R.; Nerín, C.; Gómez-Lus, R. Influence of pH and temperature variations on vapor phase action of an antifungal food packaging against five mold strains. Food Control 2015, 47, 20–26. [Google Scholar] [CrossRef]
- Simionato, I.; Domingues, F.C.; Nerín, C.; Silva, F. Encapsulation of cinnamon oil in cyclodextrin nanosponges and their potential use for antimicrobial food packaging. Food Chem. Toxicol. 2019, 132, 110647. [Google Scholar] [CrossRef]
- Silva, F.; Caldera, F.; Trotta, F.; Nerín, C.; Domingues, F.C. Encapsulation of coriander essential oil in cyclodextrin nanosponges: A new strategy to promote its use in controlled-release active packaging. Innov. Food Sci. Emerg. Technol. 2019, 56, 102177. [Google Scholar] [CrossRef]
- Ahmed, J.; Mulla, M.; Jacob, H.; Luciano, G.; Bini, T.B.; Almusallam, A. Polylactide/poly(ε-caprolactone)/zinc oxide/clove essential oil composite antimicrobial films for scrambled egg packaging. Food Packag. Shelf Life 2019, 21, 100355. [Google Scholar] [CrossRef]
- Amalraj, A.; Haponiuk, J.T.; Thomas, S.; Gopi, S. Preparation, characterization and antimicrobial activity of polyvinyl alcohol/gum arabic/chitosan composite films incorporated with black pepper essential oil and ginger essential oil. Int. J. Biol. Macromol. 2020, 151, 366–375. [Google Scholar] [CrossRef] [PubMed]
- Moreira Gonçalves, S.; Gomes Motta, J.F.; Ribeiro-Santos, R.; Hidalgo Chávez, D.W.; Ramos de Melo, N. Functional and antimicrobial properties of cellulose acetate films incorporated with sweet fennel essential oil and plasticizers. Curr. Res. Food Sci. 2020, 3, 1–8. [Google Scholar] [CrossRef] [PubMed]
- Garcés, O.; Nerín, C. Antimicrobial Packaging Based on the Use of natural Extracts and the Process to Obtain this Packaging. European Patent EP1657181A1, 13 January 2010. [Google Scholar]
- Nerín, C.; Astudillo, M.; Covián, I.; Mujika, R. Active Packaging that Inhibits Food Pathogens. U.S. Patent Application No. WO2007144444A1, 21 December 2007. [Google Scholar]
- Becerril, R.; Manso, S.; Nerín, C.; Gómez-Lus, R. Antimicrobial activity of Lauroyl Arginate Ethyl (LAE), against selected food-borne bacteria. Food Control 2013, 32, 404–408. [Google Scholar] [CrossRef]
- Haghighi, H.; Leugoue, S.K.; Pfeifer, F.; Siesler, H.W.; Licciardello, F.; Fava, P.; Pulvirenti, A. Development of antimicrobial films based on chitosan-polyvinyl alcohol blend enriched with ethyl lauroyl arginate (LAE) for food packaging applications. Food Hydrocoll. 2020, 100, 105419. [Google Scholar] [CrossRef]
- FSANZ. Application a1015 Ethyl Lauroyl Arginate as a Food Additive Assessment Report; Food Standards Australia New Zealand: Canberra, Australia, 2009; pp. 1–12. [Google Scholar]
- FDA. GRAS Exemption Claim for Ethyl-N-Lauroyl-L-Arginate Hydrochloride; U.S. Food and Drug Administration: Bethesda, MD, USA, 2005; pp. 1–4. [Google Scholar]
- Muriel-Galet, V.; Carballo, G.L.; Hernández-Muñoz, P.; Gavara, R. Ethyl Lauroyl Arginate (LAE): Usage and Potential in Antimicrobial Packaging. In Antimicrobial Food Packaging; Barros, J., Ed.; Academic Press Ltd-Elsevier Science Ltd: London, UK, 2016; pp. 313–318. [Google Scholar]
- Pezo, D.; Navascués, B.; Salafranca, J.; Nerín, C. Analytical procedure for the determination of Ethyl Lauroyl Arginate (LAE) to assess the kinetics and specific migration from a new antimicrobial active food packaging. Anal. Chim. Acta 2012, 745, 92–98. [Google Scholar] [CrossRef]
- Muriel-Galet, V.; López-Carballo, G.; Hernández-Muñoz, P.; Gavara, R. Characterization of ethylene-vinyl alcohol copolymer containing lauril arginate (LAE) as material for active antimicrobial food packaging. Food Packag. Shelf Life 2014, 1, 10–18. [Google Scholar] [CrossRef]
- Aznar, M.; Gómez-Estaca, J.; Vélez, D.; Devesa, V.; Nerín, C. Migrants determination and bioaccessibility study of ethyl lauroyl arginate (LAE) from a LAE based antimicrobial food packaging material. Food Chem. Toxicol. 2013, 56, 363–370. [Google Scholar] [CrossRef]
- Vilela, C.; Kurek, M.; Hayouka, Z.; Röcker, B.; Yildirim, S.; Antunes, M.D.C.; Nilsen-Nygaard, J.; Pettersen, M.K.; Freire, C.S.R. A concise guide to active agents for active food packaging. Trends Food Sci. Technol. 2018, 80, 212–222. [Google Scholar] [CrossRef]
- Kashiri, M.; López-Carballo, G.; Hernández-Muñoz, P.; Gavara, R. Antimicrobial packaging based on LAE containing zein coating to control foodborne pathogens in chicken soup. Int. J. Food Microbiol. 2019, 306, 1–8. [Google Scholar] [CrossRef]
- Kowsalya, E.; MosaChristas, K.; Balashanmugam, P.; Tamil Selvi, A.; Rani, J.C. Biocompatible silver nanoparticles/poly(vinyl alcohol) electrospun nanofibers for potential antimicrobial food packaging applications. Food Packag. Shelf Life 2019, 21, 1–8. [Google Scholar]
- Lazić, V.; Vivod, V.; Peršin, Z.; Stoiljković, M.; Ratnayake, I.S.; Ahrenkiel, P.S.; Nedeljković, J.M.; Kokol, V. Dextran-coated silver nanoparticles for improved barrier and controlled antimicrobial properties of nanocellulose films used in food packaging. Food Packag. Shelf Life 2020, 26, 1–9. [Google Scholar] [CrossRef]
- Inorganic Silver Antimicrobial IONPURE IPL. Available online: https://www.ishizuka.co.jp/english/material/antimicrobial/ (accessed on 10 January 2021).
- IONPURE IPL Silver-Glass. Available online: https://nanopdf.com/download/IONPUREIPL-ipl-silver-glass-kelly-registration-systems_pdf (accessed on 10 January 2021).
- European Food Safety Authority (EFSA). Opinion of the Scientific Panel on Food Additives, Flavourings, Processing Aids and Materials in Contact with Food (AFC) on a request from the Commission related to a 4th list of substances for food contact materials. EFSA J. 2004, 65, 1–17. [Google Scholar]
- Parvekar, P.; Palaskar, J.; Metgud, S.; Maria, R.; Duttae, S. The minimum inhibitory concentration (MIC) and minimum bactericidal concentration (MBC) of silver nanoparticles against Staphylococcus aureus. Biomater. Investig. Dent. 2020, 7, 105–109. [Google Scholar] [CrossRef]
- Tanaka, T.; Mizukawa, K.; Shida, K.; Kobayashi, T.; Mega, J. Application of Silver-Inorganic Antimicrobial Reagent for Dental Materials. Antimicrobial Action for Streptococcus mutans. J. Prosthodont. Res. 2000, 44, 651–657. [Google Scholar]
- Fang, M.; Chen, J.H.; Xu, X.L.; Yang, P.H.; Hildebrand, H.F. Antibacterial activities of inorganic agents on six bacteria associated with oral infections by two susceptibility tests. Int. J. Antimicrob. Agents 2006, 27, 513–517. [Google Scholar] [CrossRef]
- Li, H.X.; Ji, J.H. Inhibition of biofilm formation on the surface of anti-infection polyethylene materials. J. Clin. Rehabil.Tissue Eng. Res. 2009, 13, 4871–4874. [Google Scholar]
- Li, H.M.; Li, H.X.; Zhao, W.G.; Ji, J.H. Biofilm inhabitation and representation on the surface of polyethylene. J. Clin. Rehabil.Tissue Eng. Res. 2009, 13, 10016–10020. [Google Scholar]
- Anderson, K.P.; Butler, E.A.; Anderson, D.R.; Woolley, E.M. The solubility of silver chloride and the concentrations of silver-containing species in ethanol-water mixtures. J. Phys. Chem. 1967, 71, 3566–3569. [Google Scholar] [CrossRef]
- Braun, S.; Ilberg, V.; Blum, U.; Langowski, H.C. Release of silver from silver doped PET bottles. Food Pack. Shelf Life 2020, 25, 100517. [Google Scholar] [CrossRef]
- Martinez-Abad, A.; Ocio, M.J.; Lagaron, J.M. Morphology, Physical Properties, silver release, and antimicrobial capacity of ionic silver-loaded poly(L-lactide) films of interest in food-coating applications. J. Appl. Polym. Sci. 2014, 131, 41001. [Google Scholar] [CrossRef]
- Bayani, N.; Aroujalian, A.; Raisi, A.; Fazel, S. Surface coating of silver nanoparticles on polyethylene for fabrication of antimicrobial milk packaging films. Int. J. Dairy Technol. 2017, 70, 204–211. [Google Scholar] [CrossRef]
- Echegoyen, Y.; Nerín, C. Nanoparticle release from nano-silver antimicrobial food containers. Food Chem. Toxicol. 2013, 62, 16–22. [Google Scholar] [CrossRef] [PubMed]
- Committee of Experts on Packaging Materials for Food and Pharmaceutical Products. Metals and Alloys used in Food Contact Materials and Articles, 1st ed.; Directorate for the Quality of Medicines & Health Care of the Council of Europe (EDQM): Strasbourg, France, 2013; p. 93. [Google Scholar]
- ETHYL LAUROYL ARGINATE Chemical and Technical Assessment. Available online: http://www.fao.org/fileadmin/templates/agns/pdf/jecfa/cta/69/Ethyl_Lauroyl_arginate.pdf (accessed on 10 January 2021).
- Gaikwad, K.K.; Lee, S.M.; Lee, J.S.; Lee, Y.S. Development of antimicrobial polyolefin films containing lauroyl arginate and their use in the packaging of strawberries. Food Meas. 2017, 11, 1706–1716. [Google Scholar] [CrossRef]
- Manso, S.; Nerín, C.; Gómez-Lus, R. Antifungal activity of the essential oil of cinnamon (cinnamomum zeylanicum), oregano (origanum vulgare) and Lauramide argine ethyl ester (LAE) against the mold Aspergillus flavus CECT 2949. Ital. J. Food Sci. 2011, 23, 151–156. [Google Scholar]

| 3% Acetic Acid | 10% Ethanol | 95% Ethanol | ||||
|---|---|---|---|---|---|---|
| 107Ag | 109Ag | 107Ag | 109Ag | 107Ag | 109Ag | |
| Blank | <LOD | <LOD | <LOD | <LOD | <LOD | <LOD |
| Ag_20—LDPE | 6.74 ± 0.65 | 6.69 ± 0.64 | 2.85 ± 0.68 | 3.04 ± 0.65 | <LOD | <LOD |
| Ag_50—LDPE | 8.13 ± 0.57 | 8.05 ± 0.63 | 2.46 ± 0.06 | 2.50 ± 0.07 | <LOD | <LOD |
Publisher’s Note: MDPI stays neutral with regard to jurisdictional claims in published maps and institutional affiliations. |
© 2021 by the authors. Licensee MDPI, Basel, Switzerland. This article is an open access article distributed under the terms and conditions of the Creative Commons Attribution (CC BY) license (http://creativecommons.org/licenses/by/4.0/).
Share and Cite
Manso, S.; Wrona, M.; Salafranca, J.; Nerín, C.; Alfonso, M.J.; Caballero, M.Á. Evaluation of New Antimicrobial Materials Incorporating Ethyl Lauroyl Arginate or Silver into Different Matrices, and Their Safety in Use as Potential Packaging. Polymers 2021, 13, 355. https://doi.org/10.3390/polym13030355
Manso S, Wrona M, Salafranca J, Nerín C, Alfonso MJ, Caballero MÁ. Evaluation of New Antimicrobial Materials Incorporating Ethyl Lauroyl Arginate or Silver into Different Matrices, and Their Safety in Use as Potential Packaging. Polymers. 2021; 13(3):355. https://doi.org/10.3390/polym13030355
Chicago/Turabian StyleManso, Sofía, Magdalena Wrona, Jesús Salafranca, Cristina Nerín, María José Alfonso, and Miguel Ángel Caballero. 2021. "Evaluation of New Antimicrobial Materials Incorporating Ethyl Lauroyl Arginate or Silver into Different Matrices, and Their Safety in Use as Potential Packaging" Polymers 13, no. 3: 355. https://doi.org/10.3390/polym13030355
APA StyleManso, S., Wrona, M., Salafranca, J., Nerín, C., Alfonso, M. J., & Caballero, M. Á. (2021). Evaluation of New Antimicrobial Materials Incorporating Ethyl Lauroyl Arginate or Silver into Different Matrices, and Their Safety in Use as Potential Packaging. Polymers, 13(3), 355. https://doi.org/10.3390/polym13030355

